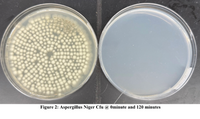

What We're Thinking About
The 2023 Ultimate Guide To Choosing an Air Purifier
Why Air Quality Matters With COVID-19 making the public hyper-aware of the risks of airborne viruses, a lack of awareness is no longer tenable for any business and a strategy that deals with the problem and allows you to bring your clients back with confidence is essential. This buyer’s guide is meant to arm you with the knowledge to make an informed decision when considering air purification solutions for your business. In general, air purifiers consist of a filter and a fan to bring in and circulate air so pollutants and particles are captured and the clean air is pushed back out as air moves through the filter. Not all air purifiers are the same and selecting the right solution may seem complicated – but we believe that it shouldn’t be. To help you decide on a solution we’ll review the importance of: Filtration Mechanism Airflow Capacity Noise Levels Cost & Confidence Filtration Mechanisms HEPA Filters at their most basic level are fans with a dense web of fine fibers, but don’t think of them like screen door filters. More accurately they are random webs of micro fibers that inherently hold a surface charge to them. Each layer is so thin that the final few-millimeters-thick filter is actually composed of hundreds of layers of these webs - and that is key to their efficacy. Even though there are pathways for air around the fibers, it is so convoluted that particles of all different sizes find their way to getting captured by at least 1 of 4 main mechanisms: sieving, impaction, interception, and diffusion. Particles that HEPA filters capture Pollen: 200 to 10 microns Mold: 100 to 3 microns Dust: 100 to 0.05 microns Dust Mite Debris: 100 to 0.5 microns Bacteria: 100 to 0.1 microns Smoke: 50 to 0.01 microns Viruses-carrying particles: 10 to 0.02 microns Viruses: 0.25 to 0.02 microns True HEPA (high efficiency particulate air) filters trace their origins back to WWII and the Manhattan project when physicists needed a way to make sure radioactive particles did not freely circulate about their workspaces. To be a True HEPA filtration device, an air purifier will have been tested and approved by one of several standardized test methods to achieve at least 99.97% filtration of 0.3 micron particles. All of the certification standards require multiple tests on each and every single filter before approval. Some filters will label themselves as “HEPA-type” or “HEPA-like,” but these filters are not verified HEPA so may not be as effective. True HEPA filters draw particles in via a fan and trap them in a web of fibers via 4 main mechanisms (illustrated above). These mechanisms combine to remove virtually all particles as shown by a NASA study and discussed below. So, reports that describe HEPA filters as only filtering particles down to 0.3 microns have misunderstood the scientific description of the filter performance and are simply wrong. 99.97% capture efficiency at 0.3 microns is the lowest capture efficiency allowable for a True-HEPA filter. For all other particle sizes, the capture efficiency is higher, ranging from 99.97 to 99.9999 and 100% for the largest and smallest particles - even at the nanoscale. Activated Carbon Filters are highly porous, high surface area substrates good at capturing odor-causing molecules. They help with volatile organic compounds (VOCs) – molecular sized gases from the built environment and cleaning and disinfecting chemicals used on surfaces and instruments. Those chemicals are important for sanitizing surfaces, but they don’t belong in the air we breathe. While that disinfectant-”clean” smell may indicate clean surfaces, it also means that there are volatile organic molecules in the air. The more open and available pores are present in a carbon filter – the more “activated” it is, and the better it is at trapping gaseous pollutants. Granulated carbon filters will be more affected (have more surface area) and will be longer lasting than any spray-on or carbon coated type of filter. The amount of material and porosity will determine how well your carbon filter works and how long it lasts before being deactivated and needing replacement. Ozone Generators, as the name implies, produce O3, a molecule that is very reactive and thus able to neutralize odors, kill mold, and react with different air pollutants to change their composition. This is because ozone is a higher energy free radical, the kind of molecules for which we take anti-oxidants like Vitamin C. US EPA reports explain that ozone can also cause health problems at high concentrations. In fact, studies from the US EPA show that low levels of ozone do not effectively destroy indoor air pollutants. Ozone is a well-documented lung irritant. The use of on-purpose ozone generators in any space is strongly opposed. Electrostatic Air Purifiers charge particles in the air so they can stick to oppositely charged plates inside the device. These devices can also produce high amounts of ozone as a byproduct Ultraviolet Germicidal Irradiation (UVGI) involves the use of specific wavelength UV-C lamps employed to damage the structure of fungal spores, viruses, and bacteria. The US EPA notes several studies in an extensive report on residential air cleaner technologies (jump to page 26) that demonstrate the potential usefulness of high energy UV-C irradiation for partial reduction of some microorganisms on internal surfaces of air cleaners but that action against airborne microbial targets is insufficient given the typical exposure times, sustained intensity, penetration ability of the light, and even resistance by some organisms. To be effective against the targets that are susceptible to UV-C, the exposure needs to be significantly longer than the few seconds seen in most air purifiers. Finally, UVGI would not be used independently of a HEPA filter so what additional benefit it brings is questionable. Photocatalytic Oxidation (PCO/PECO) uses UV light and a photocatalyst to oxidize gasses and capturecaptured particles into CO2 and other benign gasses. Depending on the molecules, some PCO/PECO have been shown to generate formaldehyde, acetaldehyde, carbon monoxide, and nitrogen dioxide. While these technologies potentially serve to clean the inside of the PCO surfaces, HEPA filters are still required to capture airborne particulates. Most of the out-sized claims from devices with this technology have been retracted. Air Flow Capacity The capacity of any air purifying unit, no matter the technology, is critical to the effectiveness of the device and has a strong impact on your health and the business health of your practice. The CFM (cubic feet per minute) rating is a measure of the cleaning speed of the purifier for removing smoke, dust, pollen, and other particulates. Your needs will depend on room size and usage, and desired ACH (air changes per hour). ACH is a calculation that takes into account the dimensions of a space and the value you select for your space will depend on several factors including local or national regulations. In general, you should aim for 5+ air changes per hour (and many more in some instances, such as dental operatories). Size of your space matters. To ensure efficacy, you need a model designed to work in the room or space size you want to address. You should always choose a model that is designed for a larger area than that which you are trying to service. First, to ensure capacity and also to give you the option to operate it at a lower, quieter setting. In fact, operating an air purifier at lower speeds can increase its capture efficiency by orders of magnitude! Noise Levels Noise is an important factor to consider not only for your clients as they come and go but even more for your colleagues and staff who are working in the space for extended periods. Look for a unit with a noise level below 70 decibels at its fastest setting. An air purifier is only useful if it is in operation. If it’s disruptive or a nuisance and users shut it off, it becomes just another piece of furniture. Cost & Confidence With all the performance possible, there are also practical considerations to weigh. Consumables & Maintenance: How often will the different filters need to be changed? Are there parts that my staff and I need to clean? Due to their function as capturers of “stuff,” all filtration media will need to be replaced at some point. The shape, size, class, and amount of filtration media will all impact the frequency of this occurrence. Warranty: What happens if a light, fuse, or some other component needs attention? Will I have to wait for someone to evaluate the problem, order parts, and schedule a fix? How much is maintenance going to cost me? Support: Does the device maker provide guidance with selecting your solution? Do they offer an evaluation of your space to determine optimal placement? How many units will you need to ensure the device is delivering on your expectations? Do they provide you with any certifications or client-facing marketing materials to support patient confidence in joining or returning to your business? The Essentials for Air Purifier Selection Evaluate Your Options With These Filtering Questions Filtration Technology ▢ Does the unit have a TRUE HEPA filter, H13 or above? ▢ Does it incorporate an activated carbon filtration component? ▢ Are you avoiding features that are ineffective and harmful? Cleaning Capacity ▢ Airflow: What are the CFM levels at different speeds? ▢ How many air changes per hour will the purifier achieve in your space? Noise Level & Interface ▢ What is the noise level of the unit at its high and medium settings? ▢ How many CFM do you achieve at an acceptable noise level for all day operation? ▢ Does the unit have an easy to view display to communicate status? ▢ How do you change settings? Do you have to do this manually? ▢ Does the unit display the current air quality to you and your staff or patients? Cost, Confidence, & Convenience ▢ What is the total annual cost of ownership? In addition to cost of purchase, what is the cost of the consumables over 1 year? 3 years? ▢ What kind of maintenance is available? ▢ Is the vendor going to be a partner to me?
Read moreBreathing Easier at Night: The Hidden Dangers CPAP Users Should Know
When it comes to a good night's sleep, we often focus on the comfort of our beds and the quality of our CPAP (Continuous Positive Airway Pressure) machines. But there's one vital factor that many CPAP users may not be aware of—the quality of the air they breathe while sleeping. The Air You Breathe Matters Clean air is crucial for our overall health and well-being, especially during sleep when our bodies work to repair and rejuvenate. Poor indoor air quality can introduce various pollutants into our breathing space, including dust, allergens, volatile organic compounds (VOCs), and even microscopic particles that can impact respiratory health. CPAP Machines: What You Need to Know CPAP machines are a lifesaver for those with sleep apnea, as they help keep airways open during sleep. These devices improve the quality of sleep, enhance oxygen intake, and ultimately lead to better rest. The Limitations of CPAP Filters While CPAP machines are highly effective at improving airflow, their filters have limitations. Standard CPAP filters are designed primarily to trap larger particles like dust and pet dander. Unfortunately, these filters may not effectively capture smaller particles, allergens, or harmful VOCs. Why Clean Air Matters for CPAP Users For CPAP users, the quality of air during sleep is of paramount importance. Breathing in contaminated air, filled with allergens or VOCs, can compromise the therapeutic benefits of CPAP therapy. It's crucial to recognize that the air you breathe while using a CPAP machine plays a vital role in your overall sleep quality and health. A Solution for Better Air Quality Enter the Jaspr Pro Air Purifier—a powerful ally for CPAP users seeking cleaner, healthier air while they sleep. The Jaspr Pro is designed with sleep in mind, offering an ultra-quiet operation that won't disrupt your rest. It features a multi-stage filtration system, including a HEPA filter, activated carbon, and a pre-filter. Here's how the Jaspr Pro Air Purifier can improve your sleep: Efficient Air Cleaning: The Jaspr Pro can efficiently remove common indoor pollutants, allergens, and VOCs, ensuring the air you breathe is fresh and clean. Whisper-Quiet Operation: Thanks to its quiet mode, the Jaspr Pro won't disturb your sleep. You'll wake up feeling refreshed and rejuvenated. Customizable Settings: You can adjust the fan speed and customize the Jaspr Pro to your preference. Whether you prefer silent operation or a gentle white noise, it's your choice. Designed for Bedrooms: The Jaspr Pro is the perfect companion for your bedroom, ensuring you have the best possible air quality during your sleep. In summary, clean air is essential for CPAP users, and the Jaspr Pro Air Purifier offers an effective solution. By investing in cleaner air, you're taking a significant step toward enhancing your sleep therapy and overall health. Don't let the hidden dangers of poor air quality affect your rest. Consider adding the Jaspr Pro to your bedroom, and experience the benefits of breathing easier at night.
Read moreThe Myth of UV: Why It's Ineffective for Air Purification
Introduction: In the world of air purification, UV technology has garnered attention for its potential to disinfect the air. However, when scrutinized closely, it becomes evident that UV's effectiveness in air purifiers is largely a misconception. In this comprehensive guide, we will delve into the science behind UV, its limitations, and why focusing on proven methods like HEPA and carbon filtration is a more sensible approach to cleaner air. The Need for Contact Exposure Time: One of the key reasons UV technology falls short in air purification is its reliance on contact exposure time. UV light requires a certain duration of exposure to effectively neutralize pathogens. In air purifiers, where air passes through swiftly, the minimal contact time renders the disinfection process ineffective. Unlike water filtration or surface cleaning, air purifiers lack the necessary conditions for UV to perform optimally. Ozone Emission: The Hidden Danger: A critical concern associated with UV technology is its emission of ozone. Despite claims to the contrary, UV-equipped air purifiers often release ozone, a harmful pollutant. Ozone, even in small amounts, can have adverse effects on respiratory health. Using an ozone detector will reveal the truth about these emissions, shedding light on the potential risks that UV air purifiers pose. Added Expenses and Energy Consumption: Apart from its ineffectiveness, UV technology introduces additional drawbacks. Installing UV components increases costs, both in terms of equipment and maintenance. Furthermore, these systems consume energy, contributing to higher electricity bills. The cumulative expenses and energy consumption make UV air purifiers an impractical choice. The Gimmick and Marketing Ploy: In an industry driven by innovation and competition, UV technology has been positioned as a marketable feature. However, the scientific evidence supporting its effectiveness in air purifiers is lacking. Many manufacturers leverage UV's reputation for germicidal properties to create a selling point, despite its minimal impact on air quality. This shift of focus from evidence-based purification to gimmicky marketing undermines the true purpose of air purification. The Jaspr Approach: Focus on the Essentials At Jaspr, we prioritize results over gimmicks. Our air purifiers rely on tried-and-true methods that have been proven to work: HEPA and carbon filtration. These technologies effectively capture particles, allergens, and odors from the air, promoting a healthier indoor environment. By avoiding the distractions of UV technology, we stay committed to delivering practical solutions that make a difference. Conclusion: In the pursuit of cleaner air, it's essential to separate fact from fiction. UV technology's shortcomings in air purification are evident, from its need for contact exposure time to the emission of harmful ozone. By choosing Jaspr's HEPA and carbon filtration systems, you embrace an approach grounded in science and proven results. Let's prioritize genuine air quality enhancement over marketing-driven myths and pave the way for healthier living spaces.
Read moreThe Truth About PCO Air Purifiers: What They Don't Tell You About Photocatalytic Oxidation
Navigating the complex world of air purification technologies requires discernment and knowledge. As innovation paves the way to cleaner air, the appeal of new methods may often mask their inherent risks. This article explores the potential shortcomings of Photocatalytic Oxidation (PCO) technology and illustrates why HEPA + Carbon filtration is the superior choice. Unraveling the Complexities: HEPA + Carbon vs. PCO Air Purifiers In the pursuit of air purification, the decision between HEPA + Carbon filtration and Photocatalytic Oxidation (PCO) becomes central. Below, we probe into the reasons why PCO may be a choice that requires caution: Drawbacks of Photocatalytic Oxidation (PCO): Ozone Exposure: PCO generates ozone, a molecule that can threaten respiratory health. Secondary Pollutants: Unforeseen byproducts may carry unknown health risks. Proven Technology: PCO is less established and lacks the track record of traditional methods. Health Concerns: Potential risks arise from the presence of unknown compounds. Unpredictable Efficacy: PCO's effectiveness varies, leaving gaps in pollutant coverage. Examining the Risks: The Hidden Dangers of PCO Selecting an air purifier means placing health and safety at the forefront. PCO presents several concerns that warrant a closer look: Ozone Exposure: More Than Just a Drawback Among the myriad issues associated with PCO technology, ozone exposure stands out as an alarming risk. Although ozone protects us from UV radiation in the atmosphere, at ground level, it becomes a respiratory hazard. The very purifiers designed to enhance our air quality may, ironically, produce ozone as a byproduct. This contradiction creates a situation where the pursuit of cleaner air results in potential health threats. Ozone's Hidden Costs Inhaled ozone can inflame lung tissues, causing symptoms that range from irritation to serious respiratory diseases over time. Beyond affecting human health, ozone can also damage materials, tarnish fabrics, and even hurt indoor plants. Making an Informed Choice: Health Above All Considering these substantial risks, choosing the right air purifier becomes a crucial health decision. Focus must remain on solutions that safeguard the well-being of everyone indoors. HEPA + Carbon: The Proven Way Forward Innovation's promise must be balanced against the potential dangers it might pose. PCO's ozone generation stands out as a major concern. The best course of action is clear: choose a solution like HEPA + Carbon filtration, which combines effectiveness with safety. Comparison of HEPA + Carbon Filtration vs. Photocatalytic Oxidation (PCO) In the quest for pristine air quality, understanding the differences between available technologies is paramount. The table below outlines key features and drawbacks of both HEPA + Carbon Filtration and Photocatalytic Oxidation (PCO): Feature / Concern HEPA + Carbon Filtration Photocatalytic Oxidation (PCO) Ozone Exposure No ozone emission Generates ozone; respiratory risks Secondary Pollutants Controlled & predictable Unintended byproducts; health impacts Proven Technology Established, decades of proven results Less established; evolving understanding Health Concerns Well understood & regulated Potential risks from unknown compounds Efficacy Across Pollutants Consistent effectiveness Variable; might not cover all pollutants Conclusion Your health and well-being should never be compromised. When it comes to air purification, choose a path that aligns with your core values. At Jaspr, we steadfastly support solutions that protect both your indoor environment and those you care about. Embrace the tested, trusted path to excellence with HEPA + Carbon filtration. Breathe in the confidence of a healthier, safer indoor space. Additional Resources: - Certain air filters using photocatalytic oxidation have dangerous by-product - What are the adverse health effects from exposure to ozone?
Read more
Luxury Air
Written by Brittany German There are practices in place that ensure we have access to healthy, clean food and water. Of the three pillars of health, food and water are always top of mind, while air, is not. Despite air being our most important biological requirement, it is probably the dirtiest and unhealthiest of our three intakes, of which we inhale 17,000 litres per day. Why settle for contaminated air, when you can breathe luxury air? How Serious is this? There are government protocols in place to clean food and water. However, there is nothing of the sort for air. Until this changes, we need to take matters into our own hands to protect ourselves and our loved ones. The American Lung Association publishes a yearly "State of the Air" report that outlines trends in air pollution around the world. This year's report shows close to 1.1 million people more than last year are living in areas with unhealthy levels of particle pollution. Studies have shown that consistently breathing contaminated air can have serious effects on your health. Unfortunately, 4 in 10 Americans risk experiencing new and/or worsening health problems. Luxury Air and Athletes We know that athletes stick to strict food regimes to optimize their nutritional intake. This includes drinking the best water. Why? By maintaining a healthy body, they in turn improve their performance. Kangen Water is a company that offers high-end technology that filters tap water in addition to producing ionized alkaline and acidic water using electrolysis. We have developed the technology to clean our water, but aren't actively paying attention to cleaning our air to the same degree. If we and athletes were all more aware of how unhealthy air affects us, then we would be able to make more informed decisions to apply to our overall health regime as we do with food and water. There can be mold and bacteria in food that we refuse to eat. There can be germs and diseases in water that we refuse to drink. There are particulates and contaminants in the air... yet we breathe them in, constantly. You don't have to be an athlete to provide your body with the best. Jaspr Air Purifiers: Built for Wildfire Air Originally engineered to combat wildfire air, Jaspr Air Purifiers are the ultimate product for filtering particulates and contaminants out of the air. Due to its advanced technology, doctors and dentists have taken notice. They are consistently choosing Jaspr as a solution to provide the cleanest air to their staff and patients in their practices. Using true HEPA filters, Jaspr Air Purifiers capture a minimum of 99.97% of particulates in the air as small as 0.3 microns in diameter. Jaspr Air Purifiers are the absolute go-to for people wanting luxury air. Jaspr provides a hands-off sense of security so you don't have to worry about what you're breathing. Using a Jaspr in addition to your existing food and water protocols ensures a long and healthy life is met. A few luxury air clients happily review how the Jaspr Air Purifier has improved their lives: Luxury air isn't just for medical and dental offices or athletes. We all deserve to be breathing clean, particulate and chemical-free air. These happy customers recognize the importance of clean, luxury air. What are you breathing?
Read more
The Effects a Humidifier has on Indoor Air Quality
Dry throats and snoring normally have people reaching for a humidifier - it seems like an easy solution. When we're starting to feel the effects of dry air, we know we need to add moisture to it. There's more to it than that. There are certainly benefits of using a humidifier, but there are risks attached. In our quest to ensure we're all breathing cleaner air, we must first consider how humidifiers affect our indoor air quality (IAQ). Is using a humidifier the right way to go? Humidifier Basics Most people know a humidifier adds moisture to the air but there's more to consider. To further understand humidifiers and their effect on our everyday lives, we need to know how they work, what types of humidifiers there are, and what we're hoping to get out of them. Let's figure out if you should actually be installing a humidifier. Types of Humidifiers and How they Work Ultrasonic humidifiers create cool or warm mist using ultrasonic sound vibrations. Cool mist humidifiers use high-speed rotating disks to produce a cool mist. Evaporative humidifiers use fans to push air through a moistened absorbent material to create humidity. Steam vaporizer humidifiers release steam by heating water with an electrical heating element. Ideal Outcome The ideal outcome of purchasing a humidifier might vary from person to person. A humidifier will add moisture to the air but this can serve many things: Ideally, you want a humidifier that adds moisture to the air, helps with any problems you have due to dry air and doesn't cause further problems. There lies the rub; humidifiers will solve one problem while creating another. 4 Factors that Determine the Success of Humidifiers 1. The Type of Humidifier Ultrasonic and impeller humidifiers are more known to expel microorganisms and minerals. Evaporative and steam vaporizer humidifiers are less likely to expel pollutants into the air but they can allow for the growth of microorganisms if filled with standing water. 2. The Type of Water The type of water used in your humidifier has an impact on how it can affect your indoor air quality. Tap water is filled with minerals so when it is aerosolized, minerals that can be digested as water become minerals that are not safe to be inhaled. To avoid dispersing these particulates into the air, use distilled bottled water. Distilled water will have a significantly lower concentration of minerals. Do not use bottles labelled 'spring', 'artesian', or 'mineral' which are rich with minerals. An experiment ran by Awair tested different types of water in a humidifier showing the difference water can make in the amount of fine dust released into the air. 3. The Humidity Level An optimal humidity level is between 30% and 50%. When humidity levels are lower than 30%, you're most likely to experience the above symptoms. When the humidity levels are higher than 50%, dust mites and mold are more likely to flourish and send additional particulates into the air causing further health problems. This is outlined well by Air Quality Canada: 4. The Cleaning Frequency It is very important to keep your humidifier as clean as possible. Where water (especially standing water) is present, germs can grow - at an even higher rate as the humidity levels climb. Anything that grows in your humidifier will blow into the air you breathe if not cleaned. To keep germs, microorganisms, and scale from affecting your air quality, clean your humidifier daily and follow the manufacturer's guidelines. The Benefits and Risks of a Humidifier Benefits A properly functioning humidifier can alleviate allergy symptoms by soothing dry coughs, eyes, throats, and noses. It can also help with bloody noses, congestion, as well as headaches, and migraines. Risks Fine Dust: Fine dust is made up of particulates with a diameter of fewer than 2.5 micrometers. You can fit 40 fine dust particles across the width of a single strand of hair. Their minute size allows them to sneak into your lungs unnoticed and thus, your bloodstream. Exposure to fine dust particles can have serious effects on your health: Too much moisture: If the humidifier isn't monitored and too much moisture is being added to the air, mold, fungus, and microorganisms will thrive. Condensate from excess moisture can deteriorate furniture, walls, and the humidifier's surrounding area. Particulates: Without diligent cleaning, your humidifier can become infested with mold, germs, and scale which will then be dispersed into the air and inhaled into your lungs. Humidifier Considerations Do you need a humidifier? Do the risks outweigh the benefits? They can as long as you make the right choices. Use a steam humidifier and clean it regularly Use distilled water Maintain a humidity level of 30% to 50% Use a HEPA air purifier to mitigate any particles that do enter the air
Read more
Indoor Air isn't as Clean as it Smells
Written by Brittany German Have you ever left your home for a day or two and come back to this weird odour, but nothing has actually changed in your home? What if I told you that odour was there before you left, but you just didn't notice? Humans are the most adaptable species on the planet, of course, our noses are not exempt from this! We actually develop a form of nose blind to the odours within a space that we are consistently in. We just don't realize it. So what does this mean for the quality of our indoor air if we can't notice odours? It means the air is not necessarily as clean as it smells... More often than not, the air inside can be far more contaminated than the air outside, or in extreme external conditions, almost as bad. Wildfire Smoke and Indoor Air Quality (IAQ) It is currently wildfire season (extreme external conditions) in British Columbia, BC. Interior BC is experiencing dangerously high levels of air contamination: The higher the number, the more severe the health effects can be to those exposed to this air for longer than 24 hours. Sensitive groups are more at risk. Residents of Kamloops and other areas in BC affected by wildfire smoke are at risk as the unhealthy air begins to affect their indoor air quality. A healthy number for indoor air in British Columbia typically ranges around 5 but during wildfire season, with outdoor air reaching levels of 200 to 250, your indoor air can reach unhealthy levels in the low 100's without you even knowing. It's easily undetected, when you've spent the day outside smelling fire all day, coming into your house the air will comparatively smell much cleaner. However, without a way to monitor the IAQ, your nose may very well be fooling you. Just because you don't smell the contaminants in the air, doesn't mean they aren't there. Especially when you've adapted to worse air. How Does Smoke Affect Indoor Air Quality? Staying indoors during wildfire season is safer, but not bulletproof. The contaminated outdoor air can enter your home through the windows, through your ventilation system, and through any cracks, joints, or openings. Your home is not completely sealed off from what's around it. Smoke Inhalation Risks Burning wood and other organic materials produce gases and fine particles. These particles can then enter your eyes or be inhaled. Once these particles are in your system, you'll likely begin experiencing some of the following symptoms: For those in the sensitive groups that have chronic heart and lung diseases, the inhaled particles can be deadly. What Can You Do To Make Wildfire Season Safer? To lower the amount of smoke you may be inhaling during wildfire season, you can do the following: Purchase an air purifier with a TRUE-HEPA filter that reads/monitors and displays IAQ Use face masks Control air circulation using your HVAC system Avoid activities that will produce even more particulates Drink water Stock up on medication The BCCDC says to "prepare for the worst" as this year's wildfires have the potential of being equally or more devastating than the previous 2016 and 2020 wildfires. Make sure you prepare for wildfire season accordingly; when you can't smell the smoke anymore, don't be fooled. Going nose blind happens when we are consistently exposed to the same smells. Don't just rely on your nose to judge your air quality. Using an air purifier that monitors and shows you accurate readings of the IAQ in addition to the above recommendations is a great way to ensure that your air inside is safe to breathe.
Read more
Patient Reassurance: Dental Office Aerosols
Dental office aerosols are not a new problem but we are constantly developing new ways to purify the air. Learn how to address the aerosols in your office and reassure your patients at the same time.
Read more
Why You Should Treat Every Patient As Covid Positive (CoV+)
Written by Brittany German Main Takeaways Dental workers have the most dangerous job Treating every patient like they're CoV+ makes everyone safer You will attract and retain patients and staff The most dangerous job in North America is the dental worker and that is before the added risks of Covid-19. There are many other jobs that sound much more dangerous. However, nuclear equipment technician and chemical plant operator rank lower than dentists and dental assistants on the danger scale - not to mention the hundreds of other jobs that seem very dangerous, but still don't outrank the risk for dental workers. During a pandemic, dental workers which includes dentists, dental hygienists, and dental lab technicians, are at an even higher risk based on their contact with others, physical proximity, and exposure to diseases. Dentists are constantly performing aerosol generating procedures (AGPs) that fill the air with hazardous bio-aerosols. These aerosols can linger in the air for hours, making dental workers the highest risk for respiratory illnesses. It's all entirely preventable. If you treat every patient like they're Covid positive (CoV+), you lower the risk of transmission, create the safest environment, reassure patients and staff, and as a result, treat more patients. How to Treat Every Patient as CoV+ In Dentistry Uncensored, Dr. Fotinos says, "Every patient that sits in the chair could potentially be infectious, and so we have to do the same thing from patient to patient." The Layering Strategy Implement a process to thoroughly screen your patients, make sure you're cleaning surfaces and filtering the air. And don't forget your PPE for the whole team: gloves, gowns, eyewear, and masks. You can find dentist specific CDC guidelines which "are intended to apply to all patients, not just those with suspected or confirmed SARS-CoV-2 infection." Creating the Safest Environment By following health and safety guidelines and layering safety protocols to treat all patients like they're CoV+, you will effectively be creating the safest environment where it is unlikely that any harmful contaminants will remain in the air. With proper air filtration using a True HEPA filter you'll see the following capture efficiency rates: Dr. Fotinos notes that he doesn't see us moving away from these protocols come the end of a pandemic, so you'll also be creating safer procedures for the future. With these protocols in place and a powerful air purifier, there is a much lower chance of airborne diseases and therefore lower rates of Covid - and all other airborne diseases - in dental offices. Patient and Staff Reassurance Creating the safest environment isn't just about safety, it's also about the feeling of security that comes with it. Both patients and staff will benefit from an environment where they know they are safe and in which they feel comfortable. Patients By explaining to your patients how you're working to keep them safe, they will not feel intimidated by all of the new protocols from the pandemic, rather they will also feel taken care of. A dental offices efforts to ensure safety will make patients feel like you're investing in their health and safety which will improve the dentist-patient relationship. This patient reassurance is crucial if you want to see them returning to your office and raving about their experience to others. Staff It is getting more competitive to hire great hygienists and dental support staff. Now more than ever, hygienists are evaluating potential employers based on the safety of the workplace. There is no denying that a great team is the backbone of any high-performing dental office. Attract and Impress Your Patients Jaspr customers use the Jaspr as a visual prompt to discuss their health and safety protocols during new patient visits. For new or returning patients who haven't yet had the opportunity to see the Jaspr air purifier at work, this is your chance to reach out with an email or a phone call. Explain to your patients how you have their safety in mind and that you'd be happy to give them a tour and an explanation of your layering strategies. Patients at dental offices with an air purifier are extremely appreciative of the investment their dentist has made to keep them and their families safe. Dr. Barakat from Villanova Dental Studio says when he opens his next dental office, even if the pandemic is behind us, "it's not going to stop me from buying these. I'll still buy them because now this is a new normal." By following suit, your office becomes a trailblazer for other dental offices and even other industries. You gain your competitive edge. What Could Go Wrong if You don't Treat Every Patient like They're CoV+? What if you don't do any of this? You raise the chances of an infectious patient coming in and transmitting an airborne disease to you, your staff and the other patients visiting your dental office. What is the cost of your business being featured in the local news as the source of an infectious outbreak? What's the Overall Outcome? Treat every patient like they're CoV+. In addition to keeping your staff and patients safe, you're helping mitigate the Covid-19 virus and other airborne diseases, you're setting an example for other offices and businesses to do the same, and as the leading authority in health and safety right now, you remain on top.
Read more